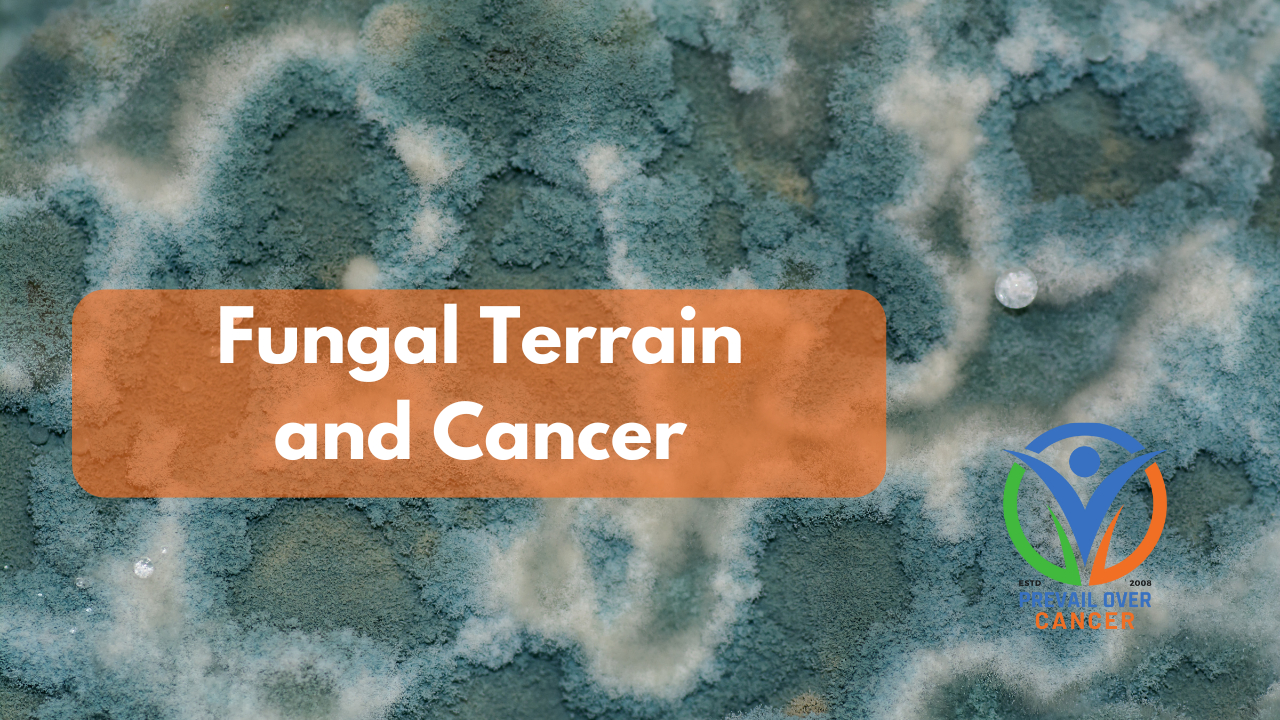

Fungal Terrain & Cancer: How Fungi, Metabolism, and Immunity Interact
Feb 18, 2026
Understanding fungal DNA in cancer tumors, terrain imbalances, antifungal foods, and how metabolism shapes fungal behavior in the body.
Researched and written by Keith Bishop, Clinical Nutritionist, Cancer Coach, Retired Pharmacist, and Founder of Prevail Over Cancer and the Prevail Protocol.
Why Fungi Are Being Found in Human Tumors
Large sequencing studies have confirmed that low-abundance fungal DNA and fungal cells appear across multiple cancer types — including breast, lung, GI, melanoma, and gynecologic tumors. These findings do not indicate infection and do not establish fungi as carcinogens. Instead, they highlight fungi as ecological participants within the tumor microenvironment.
- The Cell pan‑cancer analysis identified cancer‑type-specific fungal signatures, often co-occurring with distinct bacterial communities and immune phenotypes.
- A second Cell study confirmed the presence of fungi in GI and lung tumors and demonstrated associations with immune infiltration...



